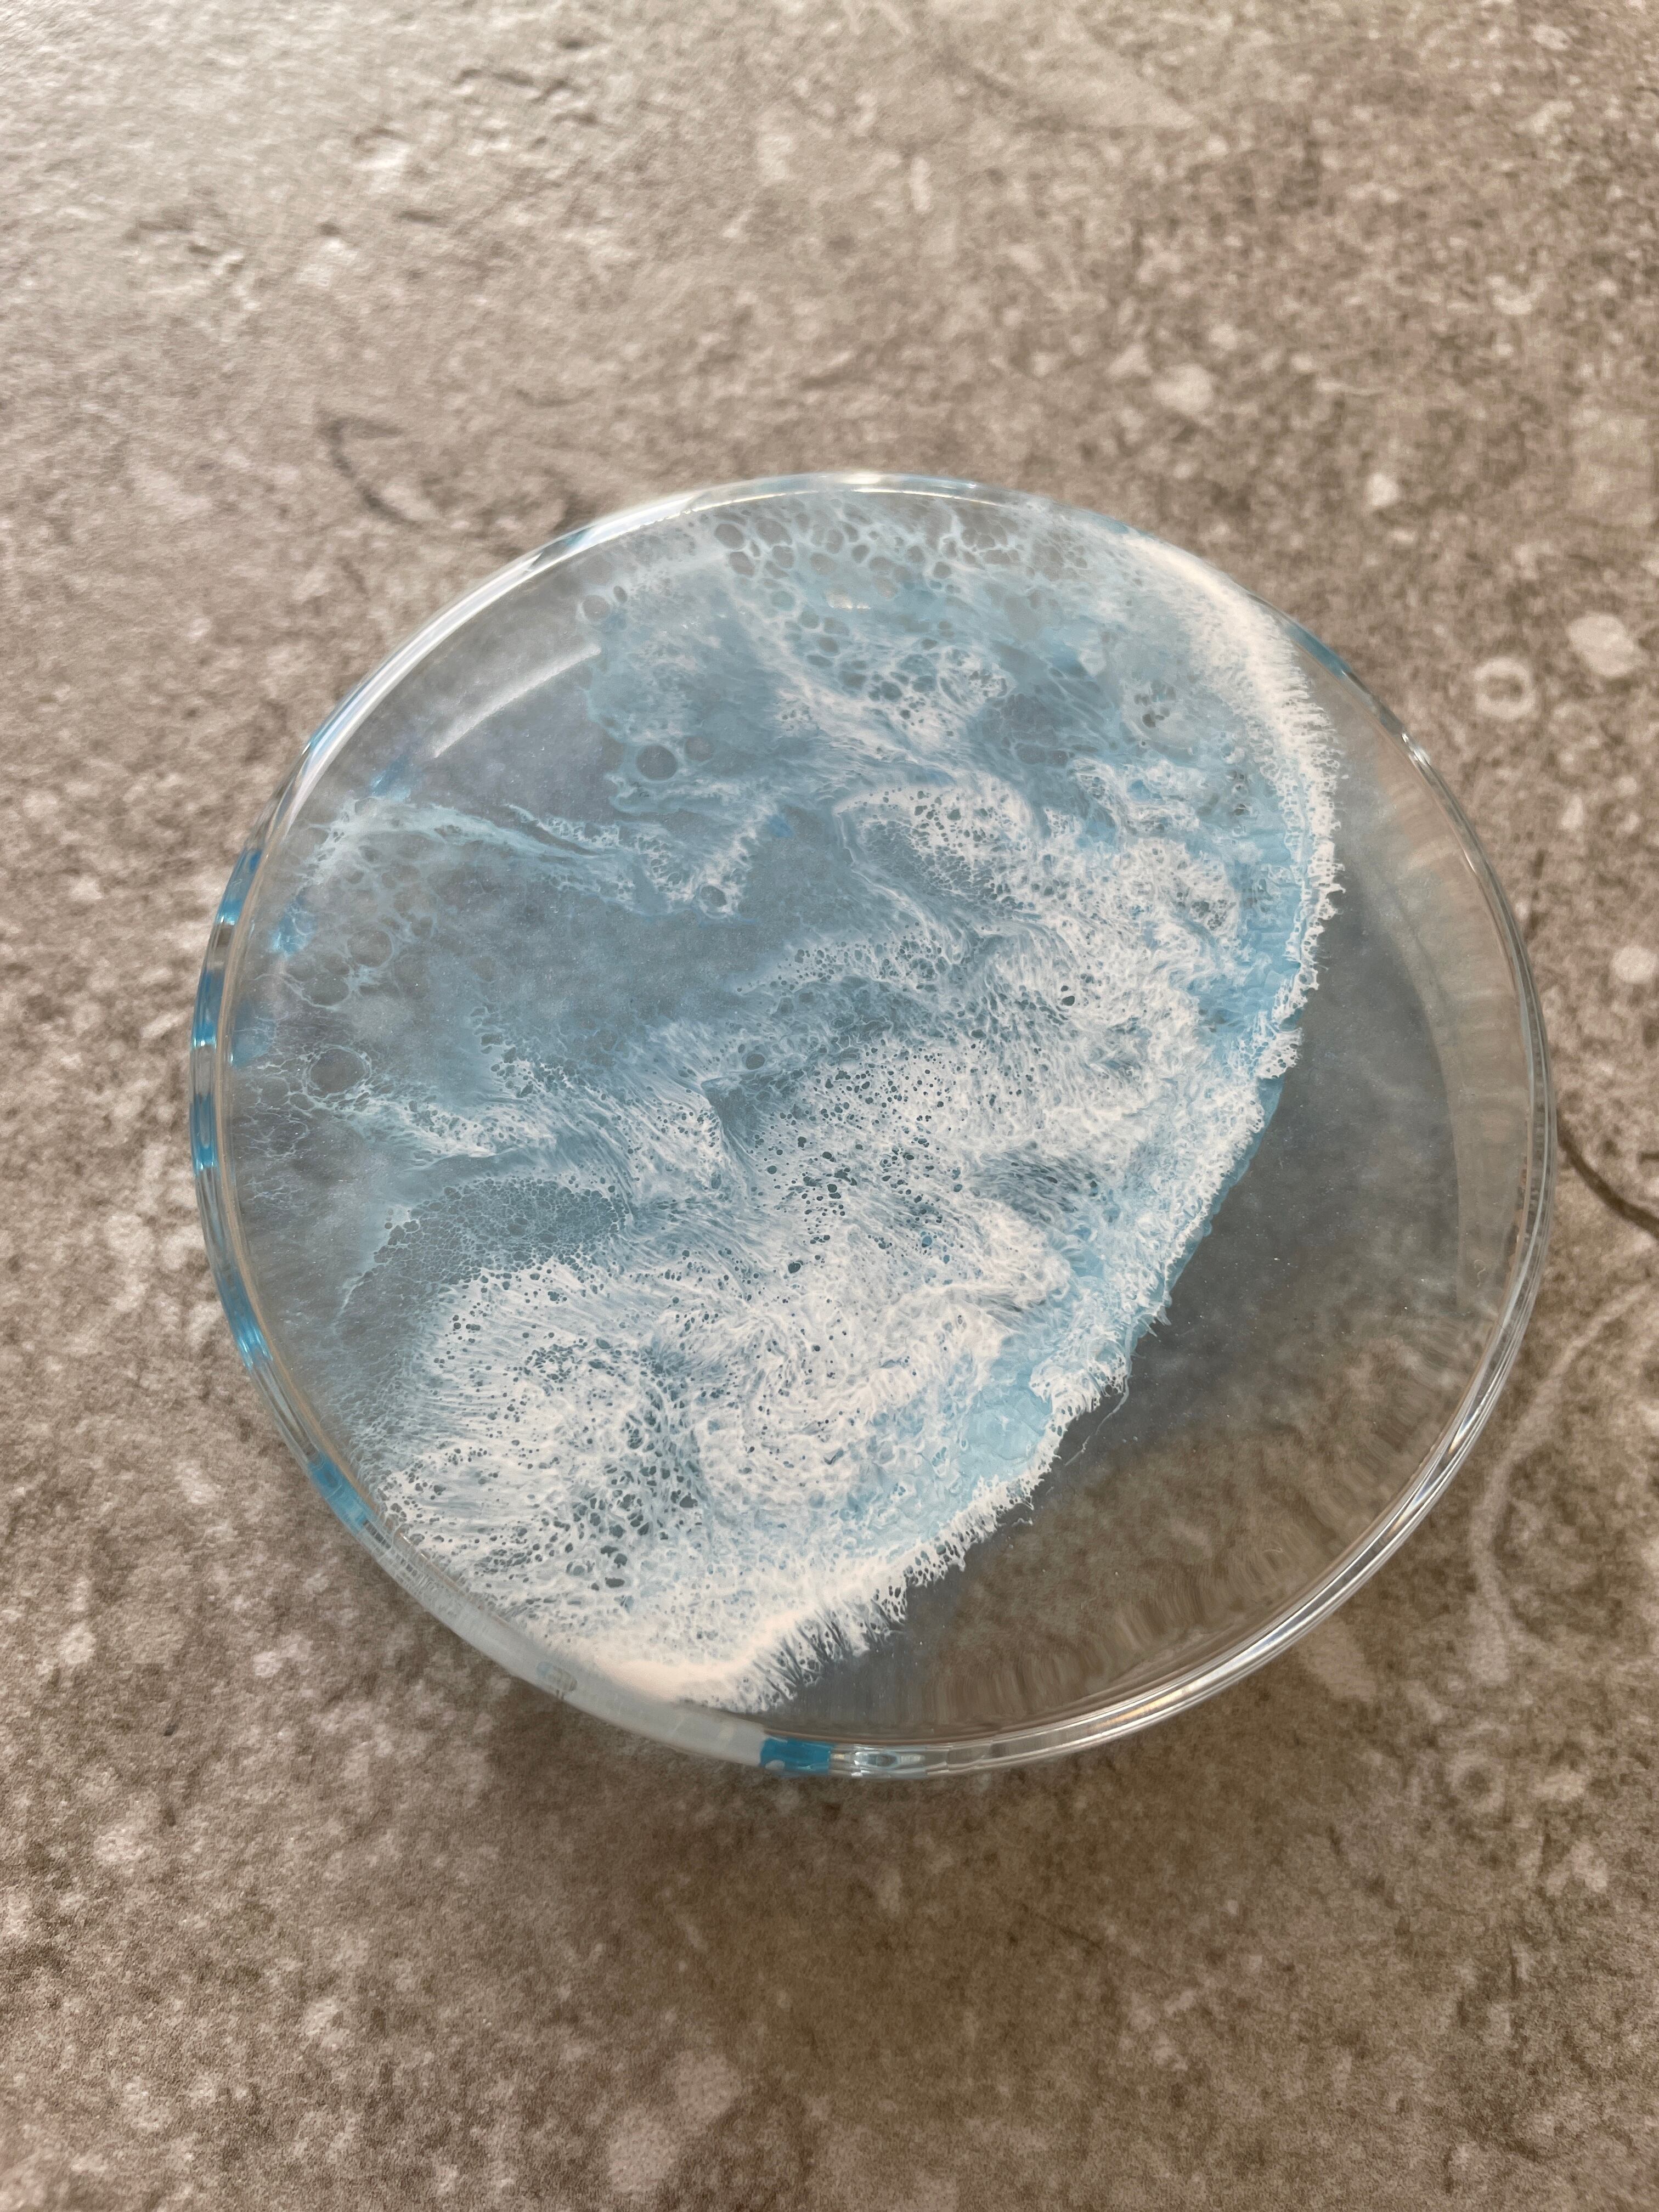

1/6
ガラスとレジンのアクセサリートレイ
¥800 税込
SOLD OUT
別途送料がかかります。送料を確認する
ガラスのシャーレにレジンを流しています
フタ部分は海
中はヒトデと砂浜
直径約9センチ
高さ約2センチ
うすく淡い色合いの海で穏やかな時間をお届けできたらと思います✨
別途送料が120円かかります。
ご購入前の注意点についてはショップ情報(ABOUT)からご覧ください。
-
送料・配送方法について
-
お支払い方法について
¥800 税込
SOLD OUT
最近チェックした商品
セール中の商品
その他の商品